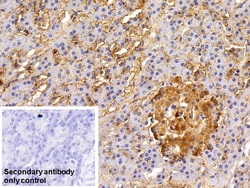
Invitrogen EpCAM (CD326) Polyclonal Antibody 200 &mu;L; Unconjugated:Antibodies,

missing translation for 'onlineSavingsMsg'
Learn More
Learn More
Invitrogen™ EpCAM (CD326) Polyclonal Antibody


Rabbit Polyclonal Antibody
Brand: Invitrogen™ PA5119097
This item is not returnable.
View return policy
Description
EpCAM (CD326) Polyclonal Antibody for Western Blot, IHC (P)
Ep-CAM (epithelial adhesion molecule, epithelial specific antigen, ESA) is a transmembrane glycoprotein expressed in the epithelium with a molecular weight of approximately 40 kDa, which functions as an epithelial cell adhesion molecule. Ep-CAM functions as a homotypic calcium-independent cell adhesion molecule, and has a direct impact on cell cycle, proliferation and metabolism of epithelial cells and fibroblasts due to its ability to rapidly induce the proto-oncogene c-myc and the cell cycle regulating genes cyclin A and E. Ep-CAM mediates Ca2+-independent homotypic interactions. Formation of Ep-CAM-mediated adhesions have a negative regulatory effect on adhesions mediated by classic cadherins, which may have strong effects on the differentiation and growth of epithelial cells. Ep-CAM overexpression was suggested to be associated with enhanced epithelial proliferation. Ep-CAM is highly expressed in human carcinomas, and is a marker for tumors of epithelial lineage. Ep-CAM is expressed on baso-lateral cell surface in most simple epithelia and many carcinoma types. Also, Ep-CAM reportedly distinguishes adenocarcinomas from pleural mesotheliomas.
Specifications
| EpCAM (CD326) | |
| Polyclonal | |
| Unconjugated | |
| EPCAM | |
| adenocarcinoma-associated antigen; CD326; cell surface glycoprotein Trop-1; DIAR5; EGP; EGP-2; EGP314; EGP40; EPCAM; Ep-CAM; EpCAM1; epithelial cell adhesion molecule; Epithelial cell surface antigen; Epithelial glycoprotein; Epithelial glycoprotein 314; ESA; GA733-2; gp40; hEGP314; HNPCC8; human epithelial glycoprotein-2; KS 1/4 antigen; KS1/4; KSA; Ly74; lymphocyte antigen 74; M1S2; M4S1; major gastrointestinal tumor-associated protein GA733-2; mEGP314; membrane component, chromosome 4, surface marker (35kD glycoprotein); MIC18; MK-1; panepithelial glycoprotein 314; protein 289A; Protein D5.7A; Tacsd1; Tacstd1; TROP1; Trop-1 protein; Tumor-associated calcium signal transducer 1 | |
| Rabbit | |
| Antigen affinity chromatography, Protein A | |
| RUO | |
| 403163 | |
| Store at 4°C short term. For long term storage, store at -20°C, avoiding freeze/thaw cycles. | |
| Liquid |
| Immunohistochemistry (Paraffin), Western Blot | |
| 0.5 mg/mL | |
| PBS with 50% glycerol and 0.05% ProClin 300; pH 7.4 | |
| Q75QW1 | |
| EPCAM | |
| Recombinant protein Epithelial Cell Adhesion Molecule. The antigen corresponds to amino acid range 25-265 of the target protein. | |
| 200 μL | |
| Primary | |
| Pig | |
| Antibody | |
| IgG |
Product Content Correction
Your input is important to us. Please complete this form to provide feedback related to the content on this product.
Product Title
Spot an opportunity for improvement?Share a Content Correction